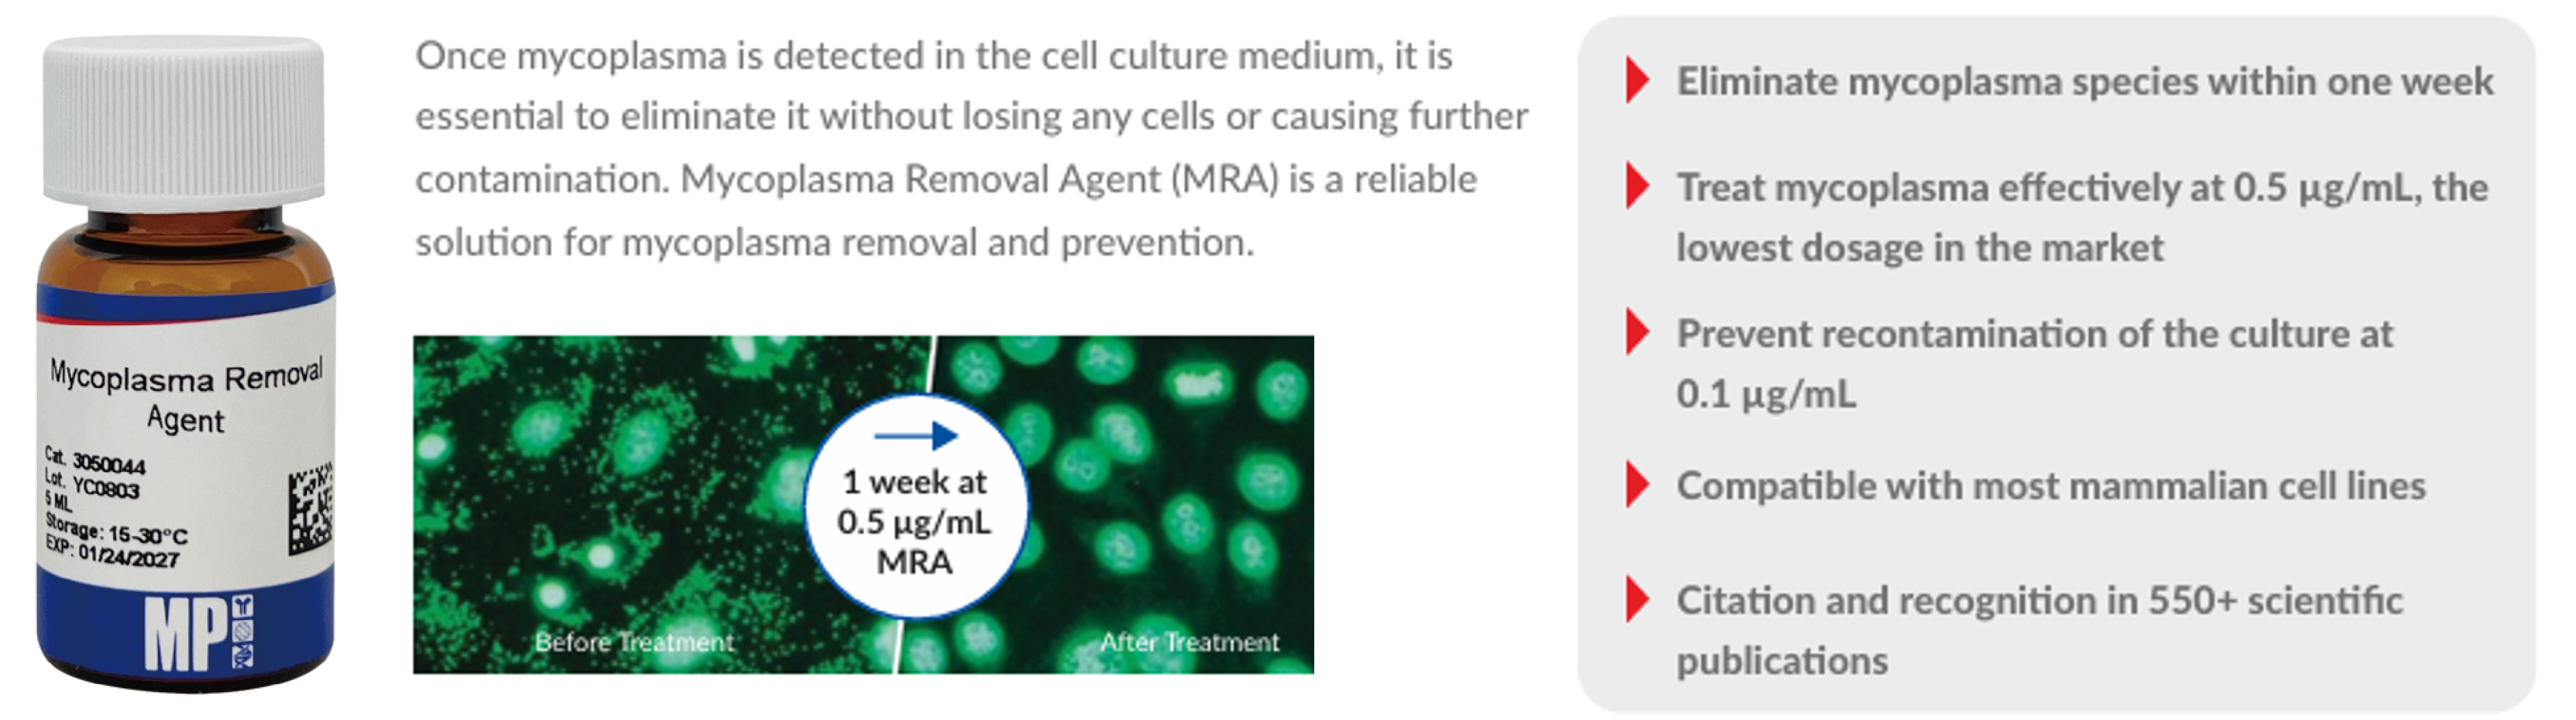

Mycoplasma contamination is one of the most critical and underestimated risks in cell culture, impacting cell growth, metabolism, and the reliability of experimental results.
Ensuring culture integrity requires more than a single solution , it demands a complete, integrated approach combining rapid detection, effective removal, and continuous prevention.
By combining DBA’s solutions for detection, removal and control, laboratories can effectively address every stage of mycoplasma control.
Detect Mycoplasma with: OPA-S102 – SAFENSURE™ Mycoplasma Rapid Detection Kit (qPCR)
A high-performance kit designed for sensitive and rapid detection of mycoplasma DNA, supporting reliable quality control workflows.
Key benefits:
- High sensitivity, even at low contamination levels
- Rapid turnaround time for efficient screening
- Easy-to-use, standardized protocol
- Suitable for a wide range of sample types
Remove mycoplasma with: 093050044 Mycoplasma Removal Agent
A proven solution for the effective elimination of mycoplasma from infected cell cultures.
Key benefits:
- Eliminate multiple mycoplasma species within one week using the lowest dosage
- Prevent recontamination of the culture at 0.1 µg/mL
- Maintain cell viability
- Compatible with most mammalian cell lines
- Sterility and low cytotoxicity
In addition to detection and removal solutions, DBA offers a comprehensive range of high-purity reagents and antibiotics to support long-term contamination control strategies, including products from:
Do not miss our page: Detect Mycolplasma in 1 Hour by Visual Colour Change